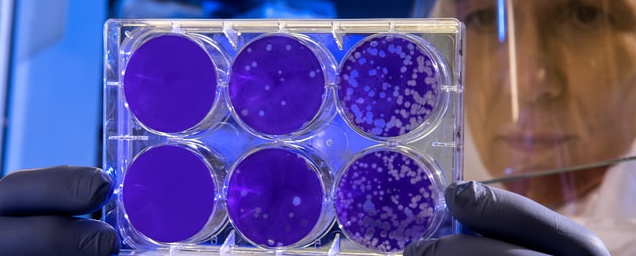

Microneedling is a minimally invasive procedure for your skin. Your healthcare provider uses thin needles to make tiny holes in the top layer of your skin. The damage helps stimulate your skin’s healing process, so it produces more collagen and elastin. These proteins are important in keeping skin elasticity.
Microneedling has numerous skin-benefiting effects and can treat a variety of aging and skin-damage symptoms, including:
You’ll likely need multiple sessions in order to achieve your desired outcomes. Most patients receive microneedling on their faces, but it can also be applied to the legs, back, neck, or other parts of the body where aging or damaged skin is visible.
Preparing for Microneedling
Pre-Microneedling Precautions for Best Results.
In order to get your skin ready for this treatment, there are two key steps. The first step is to limit your time in the sun for at least one day before unless you are wearing a sunscreen with a high SPF.
Secondly, you may need to temporarily cease using some skincare products, especially those containing Retinoids and those with acidic ingredients like glycolic acid, salicylic acid and azelaic acid.
